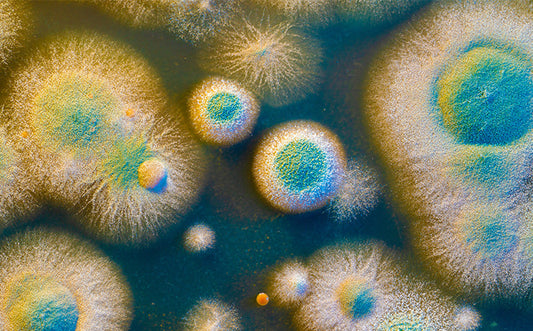

Blog

Nervous System 101
The nervous system is the body’s communication network. It connects the brain to the rest of the body through a complex system of nerves and...

A Love Letter to 11:11: The Tincture That Started It All
As we celebrate another trip around the sun, we’re reminiscing on the blend that sparked it all—our first tincture and forever fan-favourite: 11:11. A mushroom multi...

Six Years of Rainbo: A Journey Rooted in Reverence
As Rainbo approaches its 6th revolution around the sun, we sat down with our founder, Tonya, to reflect on the journey so far — the...

Earth's Hidden Healers
This Earth Day, we’re celebrating the unsung heroes beneath our feet—fungi. The recyclers, the regenerators, the silent symbionts working behind the scenes to keep Earth...

Tonya's April Musings: The Great Reawakening
Spring is here—and she’s making herself known in all the alluring ways: trees humming with the buzz of bees, the powerful scent of jasmine riding...

Ethereal Reset - A Portal to Creativity, Rest & Play
Join Us in Greece This month, I’m inviting you into my world in a deeper way—with a retreat that feels like a dream. In June,...

The Art of Slowly Living: How My Trip To Japan Shifted My Mindset For The Better
If you follow me on social media, you know I just returned from an incredible trip to Japan—and, well, I haven’t stopped talking about it. So...

Understanding Liver Health: The Springboard to Rejuvenation
As the seasons change, spring offers a fresh start not just for nature but also for our health. The liver is at the forefront...

Choosing Your Tincture: Alcohol-Based or Alcohol-Free?
Are you new to functional mushrooms? Or considering which mushroom tincture is best for you? Be sure to check out our article, Which mushroom is best for me. In...

Rainbo Forays 2023
Foray Schedule 2023 The purpose of our mushroom forays is for mushroom identification, education, connecting to nature and each other! Foray Dates Sunday October 1, 2023 - sign-up link...

Benefits of Lion's Mane
Four Benefits of Lion’s Mane Mushroom Lion’s Mane is a mushroom with a long history of use in Asian culture. It’s been used in Traditional Chinese medicine,...

Rainbo Forays 2022
We're excited to announce our 2022 Rainbo Foray schedule, lead by the Rainbo team and Antonio Cillero Rodrigo from Mushroom Guerrilla. The purpose of the forays will...

Rainbo is a B Corp!
A note from our Founder Tonya. We're officially the first mushroom company to become a B Corp! Learn about what this means for us and why...

What is a Tincture?
What is a medicinal mushroom tincture? A mushroom tincture is simply an extract of mushrooms dissolved in alcohol. An “extract” may be found in liquid...

Which mushroom is best for me?
Confused on how to choose between mushroom tinctures? We hear you! We've been getting this question from many of you. Read on if you're unsure of...

Fruiting Body vs Mycelium
When we talk about 'mushrooms' at large, we are generally referring to the fruiting body structure of the fungus. However the mushroom structure isn't a...

Rainbo Forays 2021
We're excited to announce our 2022 Rainbo Foray schedule, lead by Tonya Papanikolov, Holliday Cartar and Antonio Cillero Rodrigo from Mushroom Guerrilla. The purpose of the forays...

Rainbo is Climate Neutral Certified
Exciting news! We’re officially Climate Neutral Certified! The reality is that even after facing an unprecedented global pandemic (and everything else 2020 threw at us),...

Ethnomycology
What is ethnomycology? Ethnomycology is the combination of ethnography (the study of the customs of individual peoples and cultures) and mycology (the study of fungi)....

The Medicinal Mushroom Lexicon
Navigating the medicinal mushroom world can come with a lot of new jargon. From fungal biology, to herbal medicine terminology to our physiological and molecular responses....